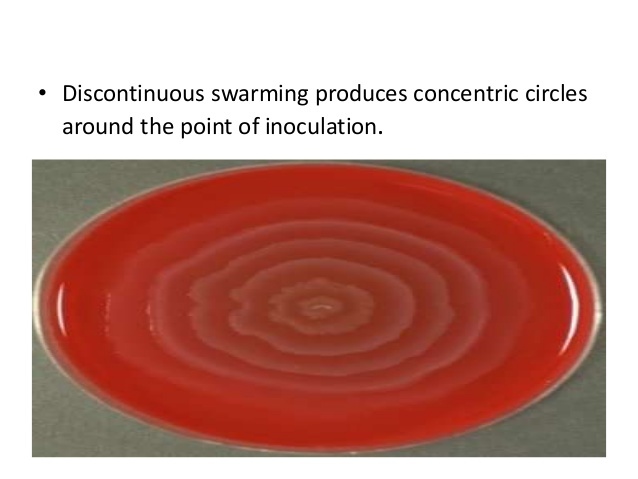

Tell me 5 things you know about Proteobacteria
- Name is from the mythological Greek God Proteus, who could assume many chapes
- Proteobacteria are gram-negative. (What does this mean?)
- Chemoheterotrophic (organisms that use organic molecules as a source of carbon and energy)
- Largest taxonomic group of bacteria
- Five Classes
- Alphaproteobacteria
- Betaproteobacteria
- Gammaproteobacteria
- Deltaproteobacteria
- Epsilonproteobacteria
Name 1 characteristic of the Alphaproteobacteria and then the bacteria that fall under this category (7 total)
- Found in low-nutrient aquatic environments
- Caulobacter
- Hyphomicrobium
- Rhizobium and Bradyrhizobium
- Argobacterium
- Nitrobacter and Nitrosomonas
Describe the characteristics of Caulobacter.
What class does it belong under?
- Produces two types of cells: swarmer and stalked
- Reproduce via budding rather than binary fission
- Belongs under Proteobacteria: Alphaproteobacteria
Which class of Proteobacteria are found in low-nutrient aquatic environments?
Alphaproteobacteria
Describe the characteristics of Hyphomicrobium and indicate which class it belongs in.
- Reproduction by budding
- Hypha or prothesca grows out of one end and bud grows at the tip of prostheca
- Belongs to the Alphaproteobacteria class
Describe the characteristics of Rhizobium and Bradyrhizobium and indicate which class they belong in.
- Fix nitrogen in the roots of leguminous plants
- Known by the common name of rhizobia
- Part of the Alphaproteobacteria class
Describe the characteristics of Nitrobacter and Nitrosomonas and indicate which class they belong to.
- Chemoautotrophic (uses inorganic chemicals as energy source (instead of light); CO2 as carbon source
- Plays important role in Nitrogen Cycle
- Nitrosomonas: NH4+ ► NO2-
- Nitrobacter: NO2- ►NO3-
Describe the characteristics of Agrobacterium and indicate which class they belong to.
- Plant pathogen; causes crown gall (think of those tumors on stalks of plants)
- Inserts a plasmid into plant cells, inducing a tumor
- Belongs to Alphaproteobacteria
Name the 3 bacteria under the class of Betaproteobacteria.
- Spirillum
- Sphaerotilus
- Bordetella
Describe the characteristics of Spirillum and indicate which class it belongs to.
- Found in freshwater
- Move via flagella
- A part of the Betaproteobacteria class
Describe the characteristics of Sphaerotilus and indicate which class it belongs to.
- Found in freshwater and sewage
- Form sheaths to aid in protection and nutrient gathering
- A part of the Betaproteobacteria class
Describe the characteristics of Bordetella and indicate which class it belongs to.
- Non-motile rods
- B. pertussis: causes whooping cough
- Part of the Betaproteobacteria class
Name the three main orders under Gammaproteobacteria
- Pseudomonadales
- Enterobacteriales
- Pasteurellales
Describe the characteristics of Pseudomonadales and indicate which class they belong to.
- Pseudomonas (genus of Gammaproteobacteria)
- Opportunistic pathogens; nosocomial infections
- Metabolically diverse
- Polar flagella; common in soil
- P. Aeruginosa: wound and urinary track infections
What can you tell me about Enterobacteriales?
- Commonly called enterics - they inhabit the intestinal tract; ferment carbohydrates
Can you name all 10 enterobacteriales discussed in the powerpoint for Chapter 11?
- Shigella
- Klebsiella
- Serratia
- Escherichia
- Salmonella
- Proteus
- Yersinia
- Erwinia
- Enterobacteria
- Cronobacter
Which Enterobacteriales causes bacillary dysentery?
Shigella

Which Enterobacteriales causes pneumonia?
Klebsiella - K. pneumoniae

What are nosocomial infections?
Which Enterobacteriales is the most common cause of nosocomial infects?
Nosocomial infections: is an infection that is acquired in a hospital or other health care facility.
Part of the Serratia Genus. Produces red pigment and is the common cause of nosocomial infections.

Which genus of Enterobacteriales causes E.coli?
Escherichia: E. Coli: indicator of fecal contamination; causes foodborne disease and urinary tract infections

Which genus of Enterobacteriales has a species that causes thyphoid fever? What is the species name?
Salmonella
- 2400 serovars
- Common form of foodborne illness
- Salmonella typhi (S. typhi) causes typhoid fever
Remember Typhoid Mary?

Which genus of Enterobacteriales forms colonies of concentric rings?
Proteus
- Swarming motility; colonies form concentric rings
Which genus and species of Enterobacteriales caused the plague?
How was the plague transmitted?
Yersinia
- Y. pestis causes plague
- Transmitted via fleas

What are plant pathogens?
Which genus of Enterobacteriales has plant pathogens?
Plant pathogen: a disease-causing organism which attacks plants.
Genus: Erwinia
Crown Rot is a good example










